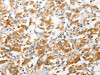
The image on the left is immunohistochemistry of paraffin-embedded Human thyroid cancer tissue using CSB-PA596504 (ANAPC2 Antibody) at dilution 1/30, on the right is treated with fusion protein. (Original magnification: ×200) The image on the left is immunohistochemistry of paraffin-embedded Human thyroid cancer tissue using CSB-PA596504 (ANAPC2 Antibody) at dilution 1/30, on the right is treated with fusion protein. (Original magnification: ×200)

Cusabio Polyclonal Antibodies
ANAPC2 Antibody | CSB-PA596504
- SKU:
- CSB-PA596504
- Availability:
- 3 to 7 Working Days
Description
ANAPC2 Antibody | CSB-PA596504 | Cusabio
ANAPC2 Antibody is Available at Gentaur Genprice with the fastest delivery.
Online Order Payment is possible or send quotation to info@gentaur.com.
Product Type: Polyclonal Antibody
Target Names: ANAPC2
Aliases: anaphase promoting complex subunit 2
Background: A large protein complex, termed the anaphase-promoting complex (APC), or the cyclosome, promotes metaphase-anaphase transition by ubiquitinating its specific substrates such as mitotic cyclins and anaphase inhibitor, which are subsequently degraded by the 26S proteasome. Biochemical studies have shown that the vertebrate APC contains eight subunits. The composition of the APC is highly conserved in organisms from yeast to humans. The product of this gene is a component of the complex and shares sequence similarity with a recently identified family of proteins called cullins, which may also be involved in ubiquitin-mediated degradation.
Isotype: IgG
Conjugate: Non-conjugated
Clonality: Polyclonal
Uniport ID: Q9UJX6
Host Species: Rabbit
Species Reactivity: Human, Mouse
Immunogen: Fusion protein of human ANAPC2
Immunogen Species: Human
Applications: ELISA, IHC
Tested Applications: ELISA, IHC;ELISA:1:1000-1:5000, IHC:1:50-1:200
Purification Method: Antigen affinity purification
Dilution Ratio1: ELISA:1:1000-1:5000
Dilution Ratio2: IHC:1:50-1:200
Dilution Ratio3:
Dilution Ratio4:
Dilution Ratio5:
Dilution Ratio6:
Buffer: -20°C, pH7.4 PBS, 0.05% NaN3, 40% Glycerol
Form: Liquid
Storage: Upon receipt, store at -20°C or -80°C. Avoid repeated freeze.
Initial Research Areas: Cell Biology
Research Areas: Cell biology